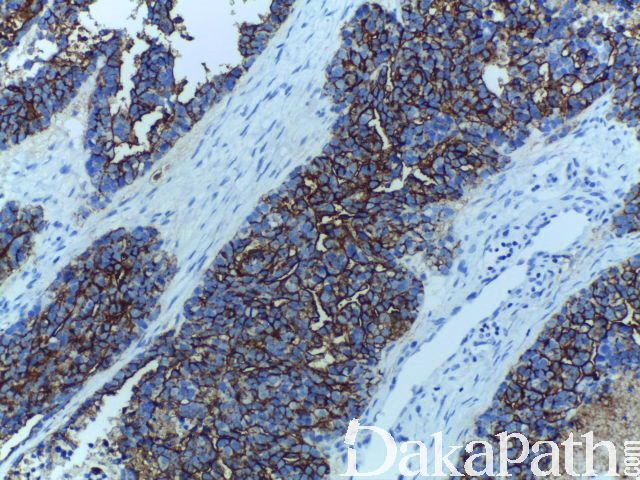

CA125

别名: Cancer antigen 125、MUC16
概述:
人卵巢恶性肿瘤的相关标记,正常卵巢无表达,但经期和孕期卵巢中存在此抗原,血清学检查广泛用于卵巢癌的检测,由 MUC16 基因编码。
信号定位: 胞膜、胞浆
在病理学中的应用:
1.79%的卵巢癌表达该抗原,与其他抗体联用用于转移性癌的鉴别诊断。
- 几乎所有卵巢浆液性腺癌表达阳性,黏液性肿瘤阴性或弱表达。结肠癌、乳腺癌、子宫腺瘤样瘤、肺细支气管肺泡癌亦可有表达。
(1) For ovarian carcinomas, use serum levels to follow response to treatment and predict prognosis (Ann Oncol 2008;19:327)
(2) In UK, recommended to use serum levels to screen women with symptoms of ovarian cancer (National Health Service Press Release)
(3) Serial measurements may be more specific for ovarian cancer
(4) Useful in immunohistochemistry to confirm ovarian origin of tumor (Am J Surg Pathol 2005;29:1482)
(5) Serum levels may have role in assessing heart failure (Clin Cardiol 2011;34:244, Eur Heart J 2010;31:1752)
High serum CA-125 levels are due to serosal fluids and serosal involvement of various diseases of ovarian or non-ovarian origin (Gynecol Oncol 2002;85:108)
Serum levels not recommended for general low-risk ovarian cancer screening due to lack of sensitivity, particularly for low stage tumors (only 50% sensitive for stage I)
商品化试剂(排名不分先后,本网站对抗体质量不负责!)
公司 | 克隆号 | 即用型(ml) | 原液(ml) | ||||
基因科技 | EPR1020(2) | 1 | 2 | 4 | 7 | 0.2 | 1 |
赛诺特 | Ov185:1 | 1 | 3 | 6 | / | 0.1 | 0.2 |
OC125 | 1 | 3 | 6 | / | 0.1 | 0.2 | |
中杉金桥 | Ov185:1 | 1.5 | 3 | 6 | / | 0.1 | 0.2 |
安必平 | OC125 | 1.5 | 3 | 6 | / | 0.1 | 0.2 |
福建迈新 | TA347 | 1.5 | 3 | 6 | / | / | 0.2 |
基因科技 | EPR1020(2) | 1 | 2 | 4 | 7 | 0.2 | 1 |
在肿瘤中的表达情况:
几乎全部阳性(≥95%的病例阳性): 中肾癌、卵巢低级别浆液性癌、膀胱透明细胞癌
通常阳性(<95%,≥75%的病例阳性): 上皮样间皮瘤、中肾瘤,NOS、子宫内膜腺癌,NOS、间皮增生、子宫内膜腺癌、腹膜原发性腺癌、宫颈乳头状浆液性癌、胰胆管腺癌、胰腺导管腺癌
经常阳性(<75%,≥55%的病例阳性): 壶腹腺癌、宫颈腺癌,非特指型、卵巢浆液性癌
有时阳性(<55%,≥35%的病例阳性): 促结缔组织增生性小圆细胞肿瘤、卵巢黏液性癌、胰腺腺癌、食管腺癌、胆管癌、卵巢透明细胞癌
少数阳性(<35%,≥15%的病例阳性): 卵巢子宫内膜样癌、结直肠腺癌、间皮瘤,NOS、卵巢黏液性交界性肿瘤/非典型增生性黏液性肿瘤、卵巢癌肉瘤、卵巢黏液性囊腺瘤、膀胱腺癌,非特指型、胃腺癌、肺腺癌
偶尔阳性(<15%,≥5%的病例阳性): 皮肤鳞状细胞癌、肝细胞癌、膀胱尿路上皮癌、肺鳞状细胞癌、乳腺浸润性癌,非特殊类型、甲状腺腺瘤
几乎全部阴性(<5%的病例阳性): 前列腺腺泡性癌、肾细胞癌、透明细胞肾细胞癌
